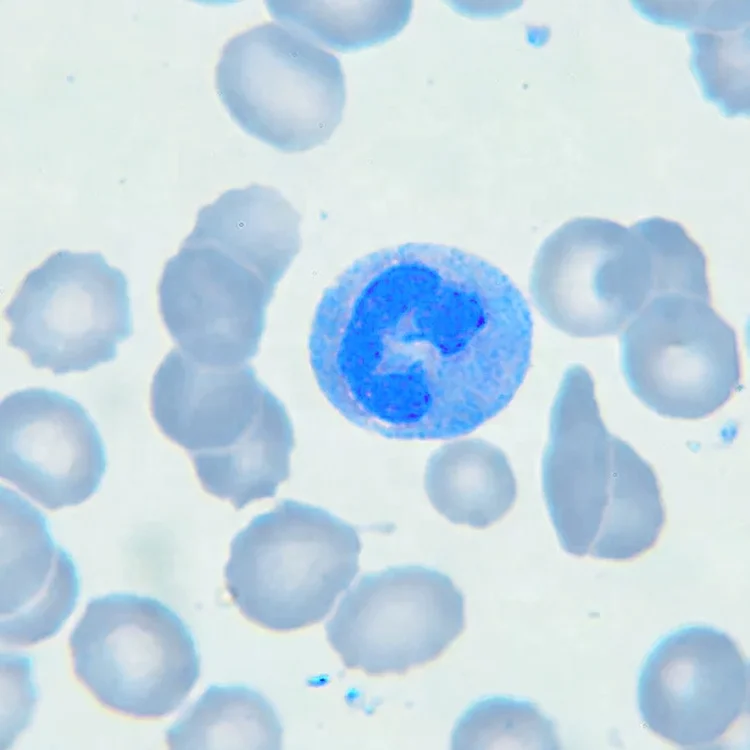
Determination standard solution ICP100mg/L ICP1000mg/L 50ml 100ml Palladium cas no 7440-05-3 Pd gray liquid

Determination standard solution ICP100mg/L ICP1000mg/L 50ml 100ml Palladium cas no 7440 05 3 Pd gray liquid
- Category: >>>
- Supplier: Weifang Economic Development Zone Hot Point Biotechnology Center
Share on (1600694472083):
Product Overview
Description
Hot-sale product
Products Description
Product Name | Palladium |
CAS | 7440-05-3 |
Average Mass | 106.42 |
Appearance | Liquid |
Color | Gray |
Usage | Determination standard solution |
MOQ | 50ml |
Packing Specifications | 50ml/bottle,100ml/bottle |
Certificate | ISO/COA/MSDS/TDS |
Product packaging
Production process
Display of test results
Company Profile
Weifang Economic Hotspot Biotechnology Center, found In 2013,has since established itself as a strategic, reliable, and dominate link in the Organic synthesis and chemical supply chains.
Also experts in providing raw materials to the adhesives and sealants, paints and coatings, agricultural chemicals, excipients, and flavor and fragrance markets.
We partner with companies across the world to establish and maintain strong relationships that allow us to source the highest quality chemical products available.
Hotspot Biotechnology applies cutting-edge sourcing strategies to your supply chain as an extension of your business. we can provide you with the best possible solutions.



Why Choose Us

FAQ

Q1:Can I get some samples?
A: Of course.If you need samples, please contact us.
Q2: How is the Product Quality confirmed before placing orders?
A: First, we will send the sample for you to test as well as our COA /testing result.
Otherwise, we can work with a third-party inspection of your choice.
Q3: What's your MOQ?
A: Normally, our MOQ is 1kg. But it can be adjusted according to your requirements.
Q4: How about delivery time?
A: Orders are shipped within 3-5 working days after payment confirmation. (Chinese holiday are NOT included)
Q5: Can I get a discount?
A: Discounts are based on quantity where is available, contact us for current details.
Q6: How do you treat quality complaints?
A: First of all, our quality control ensures our quality is consistently high. If there is a real quality problem caused by us, we will replace inferior products for you or refund your loss.
Q2: How is the Product Quality confirmed before placing orders?
A: First, we will send the sample for you to test as well as our COA /testing result.
Otherwise, we can work with a third-party inspection of your choice.
Q3: What's your MOQ?
A: Normally, our MOQ is 1kg. But it can be adjusted according to your requirements.
Q4: How about delivery time?
A: Orders are shipped within 3-5 working days after payment confirmation. (Chinese holiday are NOT included)
Q5: Can I get a discount?
A: Discounts are based on quantity where is available, contact us for current details.
Q6: How do you treat quality complaints?
A: First of all, our quality control ensures our quality is consistently high. If there is a real quality problem caused by us, we will replace inferior products for you or refund your loss.
Title goes here.
Semi-Automatic PET Bottle Blowing Machine Bottle Making Machine Bottle Moulding Machine
PET Bottle Making Machine is suitable for producing PET plastic containers and bottles in all shapes.
PET Bottle Making Machine is suitable for producing PET plastic containers and bottles in all shapes.
We Recommend
New Arrivals
New products from manufacturers at wholesale prices